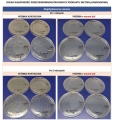
woundaid2.JPG

Producenci
Producenci
Preparat zabezpieczający świeże rany Jump It "Wound Aid" 150ml
towar niedostępny
 dodaj do przechowalni
dodaj do przechowalni
 Opis
Opis
Preparat dla koni Jump It Wound Aid – skuteczna ochrona świeżych ran
Hipoalergiczny preparat dla koni Jump It Wound Aid, stworzony z myślą o skutecznej i natychmiastowej ochronie świeżych ran, owrzodzeń oraz zmian skórnych wywołanych infekcjami. Dzięki synergicznemu działaniu dwóch substancji aktywnych, produkt zapewnia mikrobiologiczną barierę ochronną już od pierwszego zastosowania – bez bólu i bez potrzeby wypłukiwania.
Zalety sprayu na rany Jump It Wound Aid dla koni?
-
Natychmiastowe zabezpieczenie ran i owrzodzeń.
-
Bezpieczny i hipoalergiczny – nie podrażnia, idealny dla wrażliwej skóry.
-
Neutralne pH – zgodne z naturalną równowagą skóry.
-
Nie wymaga wypłukiwania – szybka i wygodna aplikacja.
-
Bez bólu i dyskomfortu – delikatny w użyciu, nie stresuje zwierzęcia.
-
Bez sterydów, alkoholu, antybiotyków i bez dopingu– maksymalne bezpieczeństwo.
-
Eliminuje nieprzyjemny zapach ran – poprawia komfort podczas zabezpieczania rany.
Dlaczego warto wybrać Wound Aid do pielęgnacji ran u koni?
Preparat Jump It Wound Aid to must-have w każdej stajennej apteczce. Niezastąpiony podczas zabezpieczania ran koni sportowych, rekreacyjnych oraz w rekonwalescencji po urazach. Dzięki nowoczesnej formule wspiera naturalne procesy regeneracji i minimalizuje ryzyko zakażeń.
Zadbaj o zdrowie i bezpieczeństwo swojego konia – sięgnij po sprawdzony preparat Jump It Wound Aid i dodaj go do swojej apteczki już dziś!
Opakowanie: 150 ml.
Zastosowanie: Bezpośrednio i obficie spryskać ranę. W przypadku zastosowania jałowego kompresu gazowego – nasączyć kompres roztworem i położyć bezpośrednio na ranę. Powtarzać 2 x dziennie lub podczas każdej zmiany opatrunku.
Uwaga: Produkt przeznaczony wyłącznie dla zwierząt. Do użytku zewnętrznego. Przechowywać w chłodnym, ciemnym miejscu.
Składniki aktywne: Chlorous acid Sodium hypochlorite.

・Kup teraz i zapłać za 30 dni
・Kup teraz i zapłać za 30 dni








Wyświetlane są wszystkie opinie (pozytywne i negatywne). Nie weryfikujemy, czy pochodzą one od klientów, którzy kupili dany produkt.